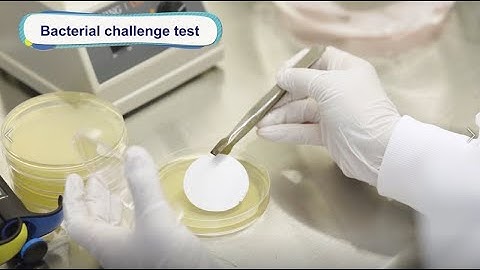
ROKI TECHNO Introduction of filter validation service

⬇ DOWNLOAD NOW
Kalau muncul iklan pop-up, tutup lalu klik tombol kembali
Download lagu Performing Filter Validations secara gratis hanya untuk keperluan promosi. Dukung artis favorit kamu dengan membeli musik original di iTunes atau platform resmi lainnya.
 🎬Acting Challenge, which one is the “Pick Me Girl”?!! 👧🏻 #acting #actingcontent #actor #netflix
🎬Acting Challenge, which one is the “Pick Me Girl”?!! 👧🏻 #acting #actingcontent #actor #netflix
ROKI TECHNO Introduction of filter validation service
ROKI TECHNO Introduction of filter validation service
 Performance Assurance Systems The new system for Hepa Filter Validation
Performance Assurance Systems The new system for Hepa Filter Validation
 Filter - Welcome To The Fold (Official Video) HD
Filter - Welcome To The Fold (Official Video) HD
 Bro Was Not Trapped 💀🔥 #edit #coldedit #viral #gang #shorts
Bro Was Not Trapped 💀🔥 #edit #coldedit #viral #gang #shorts
 Filter Sterilization Validations
Filter Sterilization Validations
 Communication Hack for Connection & Influence | #shorts
Communication Hack for Connection & Influence | #shorts
 Excel FILTER Function
Excel FILTER Function